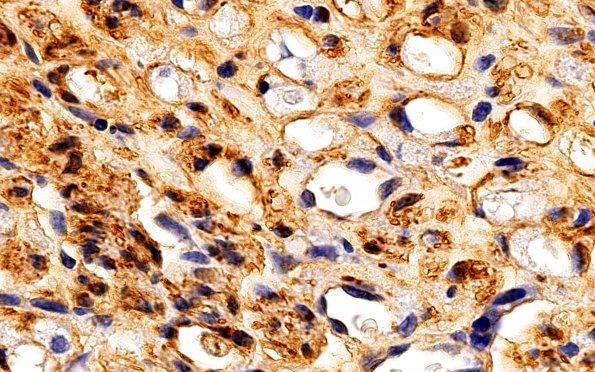
3B3 Nerve fibers (Case 3) S100 100X 1

Table of Contents
Washington University Experience | PERIPHERAL NEUROPATHY | 1 NORMAL NERVE ANATOMY | 2 Normal IHC | 3B3 Nerve fibers (Case 3) S100 100X 1
There is strong and diffuse S100 immunostaining of Schwann cells associated with all sizes of axons in the normal sural nerve. The unmyelinated Schwann cells demonstrate a more solid pattern and the myelinated axons more of a rim pattern that corresponds with the amount and distribution of Schwann cell cytoplasm. (S100 IHC)